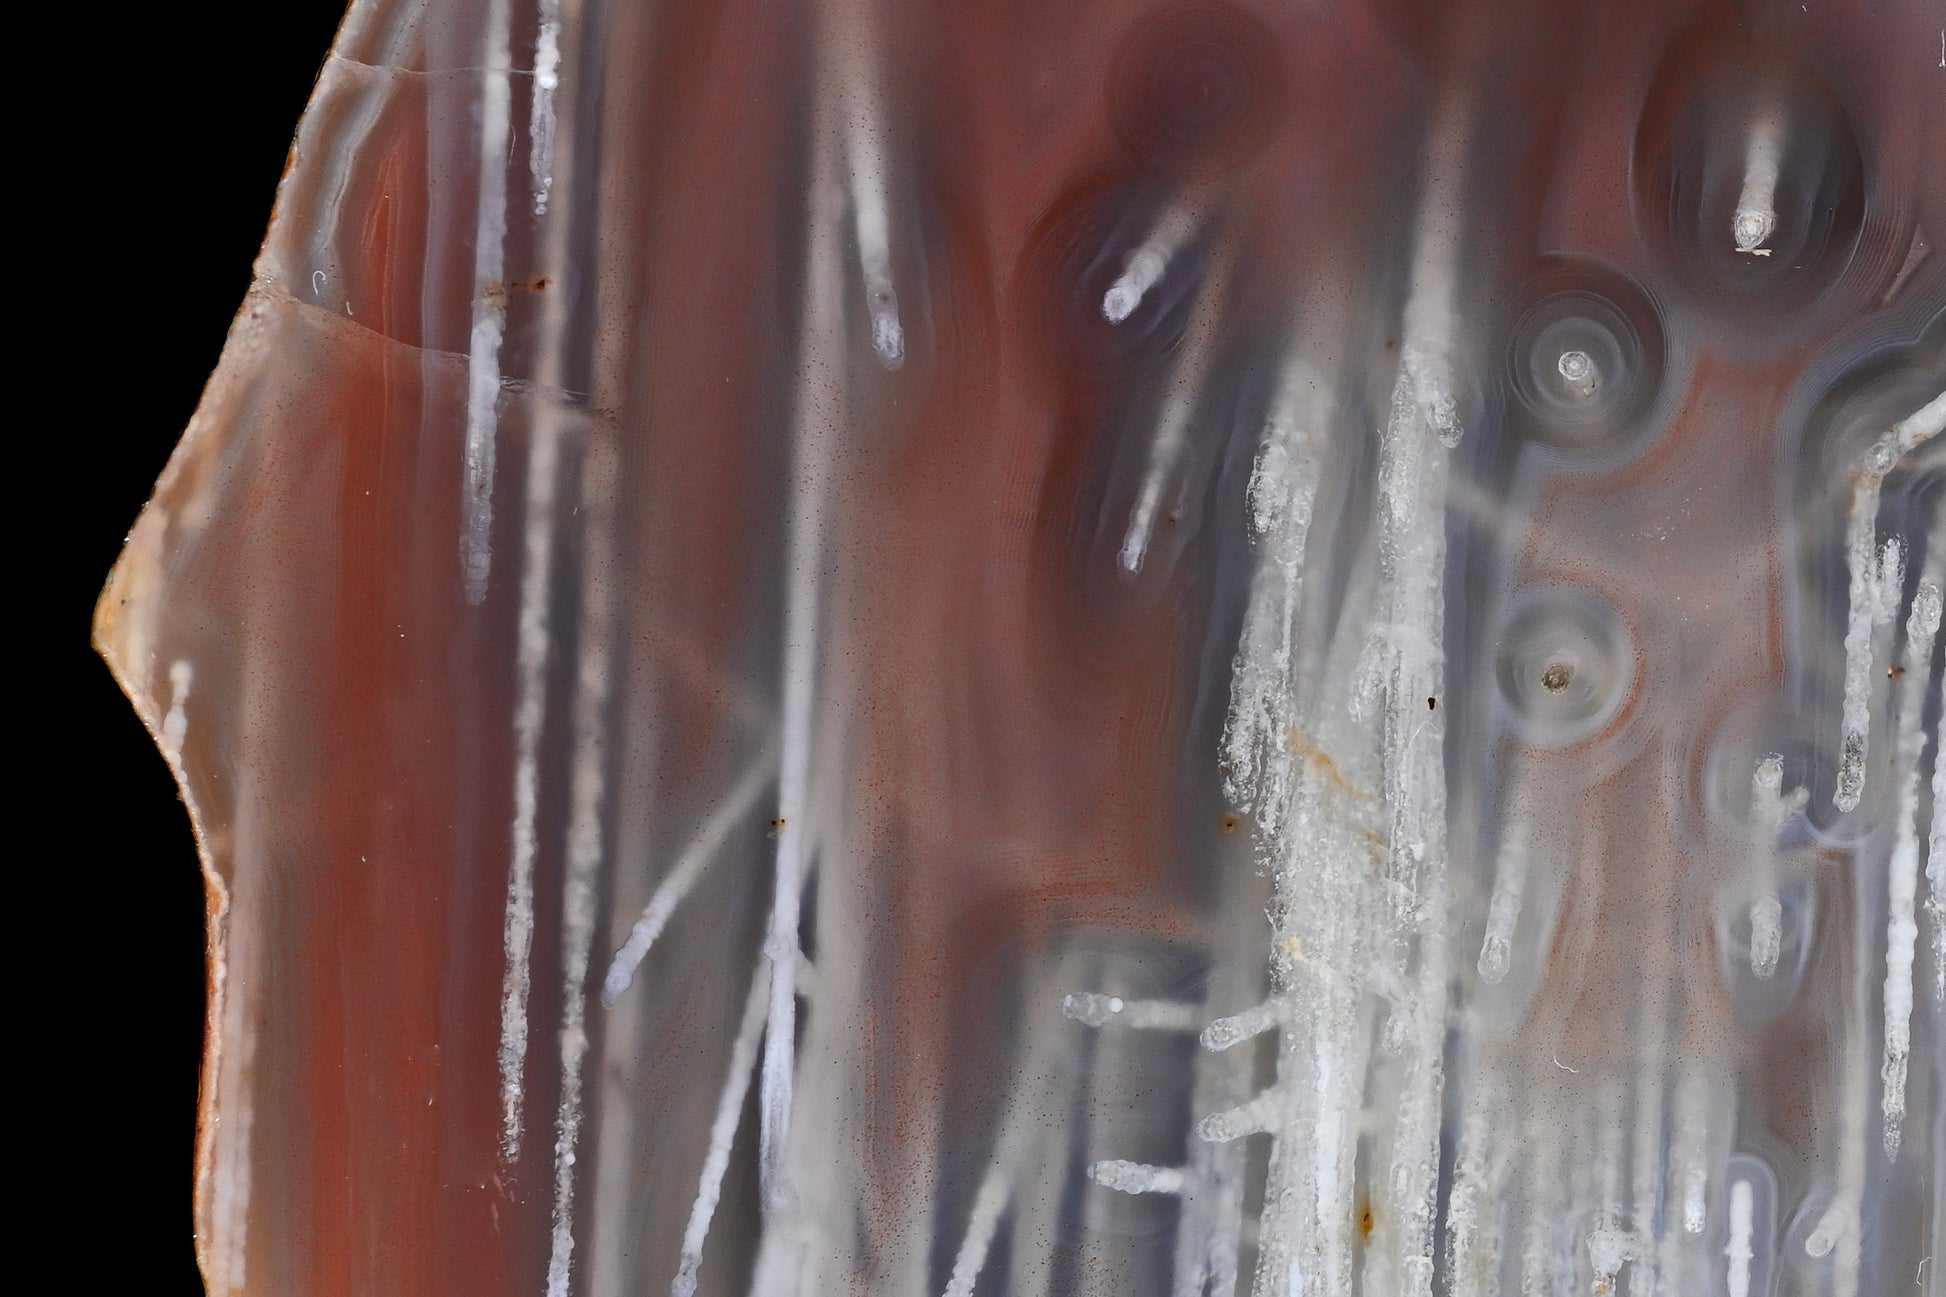

1
/
von
5
Agatebay
Mosambik
Mosambik
Normaler Preis
€200,00 EUR
Normaler Preis
€200,00 EUR
Verkaufspreis
€200,00 EUR
Inkl. Steuern.
Versand wird beim Checkout berechnet
Anzahl
Verfügbarkeit für Abholungen konnte nicht geladen werden
Tete - 75 mm - pseudomorphs
Versand
Versand
ZAHLUNG UND VERSAND
Es gelten folgende Bedingungen:
Versandbedingungen
Die Lieferung erfolgt weltweit.
Versandkosten (inklusive gesetzliche Mehrwertsteuer)
Lieferfristen
Die Lieferzeit bestimmt sich in diesem Fall nach dem Artikel mit der längsten Lieferzeit, den Sie bestellt haben. In der Regel erfolgt die Lieferung innerhalb Deutschlands bei Versand, innerhalb von 2-3 Werktagen. Die Lieferzeit ins Ausland ist 2 - 30 Tage. Beachten Sie, dass an Sonn- und Feiertagen keine Zustellung erfolgt.
Bei Fragen finden Sie unsere Kontaktdaten im Impressum.
Bei Fragen finden Sie unsere Kontaktdaten im Impressum.